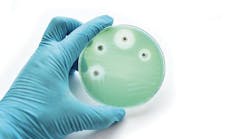
alternative to traditional antibiotics alternative to traditional antibiotics

How COVID-19 changed dental hygiene: 18 experts share key lessons for the future
Listen to the article on our podcast!
A little over five years ago, on March 16, 2020, the American Dental Association recommended dental practices close for all but emergency care due to the coronavirus pandemic. Many states also issued executive orders pausing “elective” health care.
And just like that, the profession of dental hygiene was never the same. Many hygienists left work due to health concerns, a lack of childcare, or worries about dentistry’s future. Those who didn’t were often reeling from being deemed “nonessential” care, dealing with new workplace dynamics and infection control concerns, and a patient population on edge.
As time has gone on, many of us try not to think about the spring of 2020 too much, and the discussion in dentistry has moved on as well. RDHs have new, pressing concerns, from staffing to professional self-determination. But in many ways, the conversations we’re having now are based in what happened during the pandemic.
RDH recently asked our Advisory Board: What did dental hygienists learn from the pandemic? Their insights are vital as we take stock of where the profession needs to go in the next five years.
Dental hygiene isn’t “elective”
Bethany Montoya, BAS, RDH
Key opinion leader, practicing hygienist, DIQ Clinical Insights editorial director
My biggest realization from the pandemic is that dental hygiene is not an “elective” form of healthcare. Accepting that designation has had a lasting impact on both our profession and our patient population. More than ever, dental hygienists are tasked with communicating and demonstrating how essential our contributions are to oral and systemic health.
Our operatories weren’t as safe as they could have been
Kandra Sellers, BA, RDH
Medical billing and oral-systemic health consultant
In my business of medical billing and as a clinical hygienist, I am continuingly trying to close the gap between dental and medical. What I saw with COVID is exactly that—we were seen for what we truly are, a medical specialty. We were identified to have operatories that are no different than an operating room. We are cutting into tooth, tissue, and bone all day, every day. Our profession should not be taken lightly we are no different than a surgery center and the pandemic brought this to light.
The precautions we had to take were, in my opinion, much needed to decrease cross contamination and to protect our health as clinical providers as well as those of our patients. These precautions should be more standardized and monitored and taken seriously, not state by state, instead in our country. The bacteria on your scrubs or in your hair should never leave the office, only to be brought home to your family. We are medical specialists, oral health-care professionals, and we need to keep ourselves and those around us safe from infectious disease. COVID heightened our awareness of this and our profession is better for it.
Health care is already forgetting what we learned about prevention
Anne Rice, BSH, RDH, CDP, FAAOSH
Speaker, researcher, certified dementia practitioner
It's become well-established that older individuals and those with conditions like diabetes, high blood pressure, and obesity faced a greater risk of severe COVID-19 and death. Interestingly, these same risk factors are also linked to poor oral health, including tooth loss and gum disease.
This overlap led researchers to investigate a potential connection between oral health and COVID-19 outcomes. Recent studies had evidence showing higher hospitalization and death rates among patients with significant dental damage, such as cavities, infections, and bone loss. Although most dental providers realized far before the pandemic the relationship between poor oral health and systemic complications the pandemic only solidified that understanding.
It was anticipated that considerable advancements would be made in advocating for the advantages of oral health prevention across all sectors of healthcare. However, the progress for prevention specialists, specifically dental hygienists, appears to be regressing, especially in our own siloed demographic. To me, the pandemic should have proven that oral health and dental hygienists, should be inserted into medical specialties in some way or another and that our value would be increased not diminished.
More of us are choosing to evolve rather than repeat
Amber Auger, MPH, RDH
Speaker, consultant, hygiene director, Thrive in the Op founder
The pandemic has shifted the dental hygiene space, in my human opinion, for the better. Hygienists have more opportunities for higher level of care as dental practice owners have been forced to shift their perspective on the technology they implement, their soft-tissue management programs, how they support the growth of the individual, and the culture of the practice. Many have found that they no longer want to be beholden to the office politics and have resorted to temping. Although the pandemic posed so many challenges for us across the country, I believe it helped us recalibrate on what is important for our growth both personally and professionally. I am thankful that many of us were forced to pivot, choosing to evolve over repeating!
We’re healers in more ways than one
Noel Paschke, MS, RDH
Founder and President, Ultrasonics Plus
What I learned was that RDHs not only are healers with our hands, but perhaps even more importantly, we have a our deep connection to our patients and helped them heal emotionally as we simply listened.
Our infection control guidelines work
Kathryn Gilliam, BA, RDH, MAAOSH, HIAOMT
Speaker, Lead clinical coach at Inspired Hygiene, Founder of PerioLinks and PerioBOOST
One of the things we learned as a profession is that our infection control guidelines work. We have been practicing universal precautions for decades and we have treated patients with infectious diseases, unbeknownst to us, for years without transmission. Personally, I appreciate the added infection control measures such as upgraded air filtration and surgical caps and gowns, but it gives me a sense of pride to know that when we follow our own guidelines for patient and practitioner safety, we can perform essential oral health care without harm.
When the next pandemic comes, our patients’ mouths need to be ready
Amanda Hill, BSDH, RDH CDIPC
Speaker, consultant, author, waterline safety expert
The COVID pandemic highlighted a lot of things. Certainly, infection control was something people actually paid attention to. But the one thing that stands out to me the most is the spotlight it put on the oral systemic connection. We saw people with periodontal disease fare worse than those with healthy mouths. It has changed the way I look at dental hygiene. Our role as prevention specialists is key. It's our job to preoptimize our patients' mouths so that when/if the next pandemic comes, the health of their mouth won't adversely affect their overall health.
The pandemic exposed our need for a sustainable workforce
Toni Meyerkord, BS, RDH, FADHA
Senior Manager of Academic and Industry Relations, Aspen Dental
The COVID-19 pandemic exposed and intensified dental hygiene staffing shortages, leading to increased patient loads, longer wait times, and reduced access to care. Many hygienists left due to health concerns, burnout, and personal obligations, creating a workforce crisis that forced the profession to adapt.
In response, dental hygiene programs expanded nationwide, increasing enrollment, launching new programs, and introducing flexible learning models to replenish the workforce. While these efforts are critical, challenges remain, including faculty shortages and the need for better mentorship and career support. Moving forward, we must continue advocating for workplace improvements, strengthening professional support, and ensuring sustainable workforce growth to secure the future of dental hygiene.
We learned the need for a broader scope of practice is critical
Katrina M. Sanders-Stewart, Med, BSDH, RDH, RF
Clinical dental hygienist, author, speaker, founder of Sanders Board Preperatory
Dentistry’s experience during COVID was a reckoning—a moment that forced us to confront gaps in our own infection control standards. For decades, we fixated on bloodborne pathogens, ensuring compliance with gloves, masks, and sterilization protocols, yet when an airborne virus arrived, we realized we had largely ignored the impact of aerosols and indirect droplet transmission.
Meanwhile, we doubled down on patient education, emphasizing prevention, only to later learn that poor oral health wasn’t just a concern for teeth and gums—it was a predictor of severe COVID outcomes, including a staggering nine times higher risk of death.
At the same time, tension within practices escalated as hygienists, who are infection control experts, found themselves battling an "us vs. them" dynamic with practice owners who bore ultimate responsibility for both patient care and business survival.
But perhaps the most significant lesson still lingers: what is dentistry’s role in systemic diseases that the public assumes have nothing to do with the mouth? How do we position ourselves alongside medical colleagues to contribute meaningfully to public and community health?
I’m in awe of the hygienists who took action—not literally rolling up their sleeves (because, infection control, of course!)—but diving into CDC guidelines, educating patients, creating continuing education, and expanding their scope to include vaccinations. This moment in dentistry is more than just a challenge; it’s an opportunity. Those advocating for broader scopes of practice aren’t just pushing boundaries; they’re ensuring we’re equipped to face the next public health crisis head-on.
COVID exposed deep dissatisfaction with poor leadership in dentistry
Josey Sewell, RDH
Entrepreneur, dental practice management expert
The Great Resignation, fueled in part by the collective pause brought on by COVID-19, revealed a deep dissatisfaction with poor leadership. For the first time, people around the world reflected on their mortality and questioned whether their work was fulfilling and impactful.
Dentistry has long faced a leadership crisis, and the mass exodus of professionals—especially hygienists—was not just about the fear of exposure to COVID-19. It was also about seeking workplaces where psychological safety, meaningful work, kindness, respect, and a sense of contribution truly mattered. People want to work with leaders they trust and colleagues they enjoy, making it more critical than ever to create environments that foster these values.
Delays in preventive care have consequences
Amy Lemons, MEd, BSDH, RDH
Assistant professor of periodontics
Reflecting on the effects of the COVID-19 pandemic on the dental hygiene profession reiterated for me the importance of regular preventive care. During this time and for a while after, I saw several patients whose appointments had been delayed either due to closed dental offices or fear of COVID-19 spread. Many of these patients had signs of periodontal disease progression and increased caries because of the delay in care.
Additionally, I developed a greater appreciation for the ultrasonic scaler. Where I work, we were not allowed to use the ultrasonic scaler at all for about six months due to the fear of spread through aerosols, and then only for scaling and root planing or more advanced procedures for a year after that. It was harder on both me and my patients, and I don’t think many patients received as positive results from periodontal therapy as they would have received with ultrasonic instrumentation.
Dental hygiene education has emerged stronger
Marianne Dryer, MEd, RDH
Director of Dental Sciences at Cape Cod Community College
Five years post-COVID, dental hygiene education has evolved significantly in response to the challenges and lessons learned from the pandemic. Here are some reflections:
Hybrid and digital learning is here to stay: The pandemic accelerated the adoption of virtual learning at Cape Cod Community College. While hands-on training remains essential, hybrid models integrating online lectures, virtual simulations, and digital case studies have proven effective in enhancing accessibility and flexibility for our students.
Infection control standards are permanently elevated: Strict infection control protocols implemented during COVID-19 have become the new standard at our college. Enhanced PPE usage, improved air filtration, and stricter disinfection protocols are now deeply embedded in clinical education and practice. My hopes are these standards are continuing post-graduation.
Greater emphasis on mental health and resilience: The pandemic highlighted the emotional and mental health challenges faced by students and our faculty. Our college has incorporated more wellness initiatives, stress management resources, and discussions around generalized anxiety post-pandemic.
Workforce shortages and changing student demographics: COVID exacerbated workforce shortages in dental hygiene, leading to increased applications and a more competitive process regarding admissions. We are also seeing shifts in student demographics, including more non-traditional students seeking second careers in dentistry.
The rise of teledentistry and digital dentistry: The pandemic also provided various funding opportunities for our institution which allowed us the ability to purchase items such as virtual reality software and digital dental solutions giving our students more exposure to digital scanning, CAD/CAM, and AI-driven diagnostics.
Adaptability is a core competency: Perhaps the biggest lesson I have learned as a director is the importance of adaptability. Our faculty and students had to pivot rapidly during COVID, and that resilience continues to shape how our program is designed and delivered.
Patients are less trusting than they used to be
Connie Simmons, MA, BSDH, RDH
Lead coach at Inspired Hygiene, member of the Dental Codeology Consortium
The pandemic has changed a lot of things for the world's population. One thing that sticks out to me is the loss of trust factor. With what we now know about all of the misinformation stemming from the pandemic, it has caused many people to be less trusting. This lack of trust has manifested in our profession as patients questioning more recommendations than they ever have. There just seems to be more people doing their own research before being eager to readily accept treatment or recommendations. To me, this seems to have increased greatly over the last few years. This can cause frustration and lack of confidence in treatment plans for providers.
Don’t shy away from change
Melissa Turner, BASDH, RDHEP, EFDA
Executive, consultant, speaker, mobile and teledentistry expert
It's been five years since the pandemic, and here's what I've learned in this time: In times of unprecedented change, don't shy away—step up and embrace it! Work it to your advantage. Take change by the horns and guide it to where you need it to go. Find your new ground. Take a few steps forward, a few steps back, and a few steps forward again. Change is a dance and life is a dance. It's simply up to us to create the music that weaves it all together in a miraculous rhythm and melody—the dance that keeps us moving forward day by day.
We’re more resilient than we thought
Annie Walters, MSDH, RDH
Educator, consultant, author
Five years since the seismic shift in infection control practices. Five years since oral health care providers were put on the map when looking at coronavirus risk factors. Five years since dental hygienists everywhere took a hard look in the mirror and decided whether this career was meant for them.
To those dental hygienists on the front lines that put their patients before everything else, I thank you. The closure of dental offices was a scary and uncertain time; however, I found comfort in my hygiene team and our patients that looked to us for guidance. Although the pandemic represented significant stress, heartache, and frustration for many, it also showcased the strength and resilience of health care professionals everywhere that rose to the occasion and found a way through. Five years later, we carry the research and practice guidelines with us as the oral systemic connection has never been more apparent.
The pandemic showed us we’re practicing “sickCare,” not “healthCare”
Machell Hudson-Hoover, RDH, CHC, FAAOSH
Integrative Dental Coaching Founder and CEO, Head of Oral Systemic Health and Hygiene Growth for the Clinical Calibration Institute
The COVID-19 pandemic revealed profound challenges in our American health care system and highlighted the urgent need for change. While we mourn the losses, it has further fueled my passion along with numerous others for meaningful advancements in health care. We are finally getting to push this oral-systemic movement forward.
I wholeheartedly believe this is not just an opportunity for dental hygienists to prioritize prevention and early detection—it should be for the whole team. By collaborating with our dental health care team, our patients, and then our medical partners, we can uncover root causes and implement real solutions. This is no longer practicing “sickCare” but instead real “healthCare,” and it feels amazing.
In 2019, the oral systemic movement was told we were a niche perspective. Now this proactive care is being embraced, not only focusing on prevention and early detection of disease for our patients, but also integrating lifestyle medicine approaches into our personal and professional lives. Together, we health-care professionals working together with our patients can create a healthier future rooted in compassion and genuine care. If you know me, you know I love this with my whole heart.
We shouldn’t be destroying our bodies to provide treatment
Katrina Klein, RDH, CEAS, CPT
Speaker, author, ergonomics consultant, certified personal trainer
When we came back to work, we were hit with the harsh reality that we are not a “well” country. We (and our patients) have countless comorbidities which were brought to light during the pandemic. We learned that we must take better care of our bodies because succumbing to illness faster when chronically unwell isn’t limited to patients.
We learned that workload absolutely contributes to body pain. Not just the number of teeth that we scrape, but the way we now practice: the extra PPE, the intensity of the therapy delivered, the time and mental gymnastics required for in depth health history reviews, the plethora of screenings and assessments to determine the needs of our patients. Mental exhaustion contributes to physical pain, which was clearly demonstrated during the pandemic.
We learned that sleeping enough, exercising to some degree, eating nutritious foods that prevent metabolic disorders, and hydrating enough can’t be ignored. It’s all a drain on our body battery in ways that can feel equal to tenacious subgingival calculus in a 9 mm pocket. Dentistry’s continued efforts to expose the oral systemic link is vital to our profession and patients, but it comes with a caveat: Too much work in too little time with no care for basic human needs leads to mistakes, burnout and injury.
Gone are the days of squeezing in “a quick prophy.” Nothing can be “quick” anymore—for our patients or for us.
Advocacy is simply not optional
Joy D. Void-Holmes, DHSc, BSDH, RDH
Founder of Dr. Joy, RDH and JELL-ED
The COVID-19 pandemic underscored the critical role of advocacy within the dental hygiene profession, emphasizing that this responsibility must extend beyond times of crisis. Hygienists must possess the confidence and courage to consistently champion the standards of care that define our field. This includes adherence to CDC and OSHA guidelines—not as reactive measures during public health emergencies, but as routine practices that safeguard both clinicians and patients.
Advocacy must also encompass the needs of our patients by ensuring adequate appointment times to deliver comprehensive care and utilizing well-maintained equipment to perform procedures effectively and safely. Beyond patient-focused advocacy, we must prioritize self-advocacy. Hygienists should assert their value and boundaries in the workplace, fostering environments that promote respect and professionalism.
Additionally, one significant lesson from the pandemic is the importance of advancing one’s knowledge and skillset. Elevating education, both through didactic learning and hands-on clinical training, positions hygienists to adapt to future challenges and innovations within the profession. Lifelong learning enhances our ability to lead, educate, and advocate for the standards that ensure excellence in patient care and public health.
The past few years have reinforced that advocacy is not optional but an integral responsibility of every dental hygienist. By using our voices effectively and continuously, we can protect our profession, uphold superior standards, and contribute meaningfully to the broader healthcare community.
Stay engaged in the future of dental hygiene
About the Author
Amelia Williamson DeStefano, MA
Amelia Williamson DeStefano, MA, is group editorial director of the Endeavor Business Media Dental Group, where she leads the publication of high-quality content that empowers oral-health professionals to advance patient well-being, succeed in business, and cultivate professional joy and fulfillment. She holds a master's in English Literature from the University of Tulsa and has worked in dental media since 2015.
Updated May 16, 2023